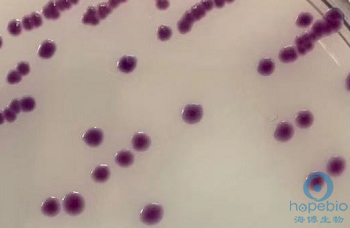
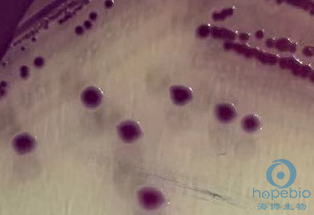
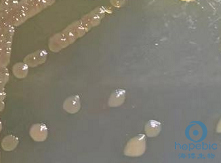
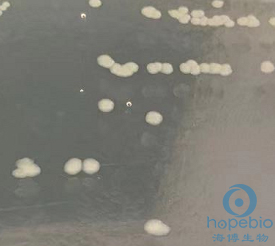
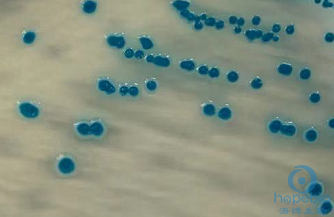

海博微信公众号
海博天猫旗舰店




一、标准
《GB4789.4-2016 食品安全国家标准 食品微生物学检验 沙门氏菌检验》
二、沙门氏菌简介
沙门氏菌为肠杆菌科的无芽孢革兰氏阴性杆菌,多数有鞭毛,动力强,可引起食物中毒,常存在于蛋类食品或受到粪便污染的食品中。沙门氏菌属种类繁多,超过了2000个菌型,表面的抗原较为复杂,生化反应特征也存在差异。按照生化反应特征,GB4789.4中将其主要划分为6个生化群。大多数沙门氏菌不发酵乳糖、赖氨酸脱羧酶阳性、产硫化氢、发酵葡萄糖产酸产气、尿素酶试验阴性,也有少数沙门氏菌能发酵或迟缓发酵乳糖(亚利桑那沙门氏菌),不产硫化氢(甲型副伤寒沙门菌、部分猪霍乱沙门氏菌等)。
三、沙门氏菌选择性分离培养
1.样品处理和预增菌
无菌操作取25g样品加入至含225mL的BPW均质袋、均质杯或合适的容器中混匀,36±1℃培养8-18h。
注意事项:若检验样品有尖锐棱角或硬块时,使用均质袋有破损漏液风险,宜采用均质杯或其他容器进行处理。
2.选择性增菌
分别取1mL的BPW增菌液加入至10mL的SC和TTB培养基中,SC置于36±1℃培养18-24h,TTB置于42±1℃培养18-24h。
注意事项:(1)标准中选用了两种培养基进行选择性增菌培养,目的是为了适应多种沙门氏菌的生长,降低漏检率,必须两种培养基同时使用;(2)SC培养温度是36±1℃,而TTB的培养温度是42±1℃,必须严格按照参考的标准中规定的温度进行培养。详情可参考SC培养基原理及现象和TTB培养基原理及现象。
3.选择性分离
这一步是检验过程中至关重要的一步,沙门氏菌种类繁多,生化反应和生长特征也有所不同,即使在同一种选择性分离平板上也有多种菌落形态。标准中要求使用亚硫酸铋琼脂,再从XLD、HE和显色培养基至少选用一种培养基。同时使用两种不同的培养基,也是为了提高检出率。
(1)亚硫酸铋琼脂
标准中沙门氏菌菌落特征描述:菌落为黑色有金属光泽、棕褐色或灰色,菌落周围培养基可呈黑色或棕色;有些菌株形成灰绿色的菌落,周围培养基不变。
亚硫酸铋琼脂倾向于分离伤寒类沙门氏菌,典型的沙门氏菌可在亚硫酸铋琼脂上生长良好,产硫化氢的沙门氏菌菌落通常为黑色,并有金属光泽,周围培养基可呈现黑色或棕色;不产硫化氢的沙门氏菌菌落通常为灰绿色,周围培养基不变色。部分肠杆菌在此培养基上有微弱生长,菌落通常为灰绿色,也有少数产硫化氢的细菌菌落呈黑色有金属光泽,与典型沙门氏菌特征类似,对可疑菌落的挑选造成干扰。
伤寒沙门氏菌在BS平板上36±1℃培养40h,菌落呈黑褐色,周围变棕色,菌落有金属光泽。
BS平板-伤寒沙门氏菌CMCC50071
亚利桑那沙门氏菌在BS平板上36±1℃培养40h,菌落呈亮黑色,有金属光泽,菌落周围变棕色。

BS平板-亚利桑那沙门氏菌CMCC47001
甲型副伤寒沙门菌(不产硫化氢)在BS平板上36±1℃培养40h,菌落呈灰绿色,无金属光泽,菌落周围不变色。
BS平板-甲型副伤寒沙门菌CMCC50093
在BS平板上挑取可疑菌落时,优先挑取黑色带金属光泽菌落,其次再挑选灰绿色菌落。
注意事项:BS平板成分较不稳定,应按照标准第一天配制,第二天使用,放置时间不超过48h,存放时间过长会影响培养基使用效果。详情可参考BS原理及使用方法和BS平板配制后不同使用时间目标菌的生长对比。
(2)木糖赖氨酸脱氧胆酸盐琼脂(XLD)
培养基简介:XLD培养基中含有铁盐和硫酸盐,产硫化氢的细菌可还原硫酸盐生成硫化氢,与铁盐反应生成黑色物质,使菌落带有黑色中心;培养基中含有少量的木糖及较多的蔗糖和乳糖用于细菌糖代谢初步判断,不能发酵乳糖或蔗糖的细菌通常呈无色或红色,能发酵乳糖或蔗糖的细菌呈黄色。
标准中沙门氏菌菌落描述:菌落呈粉红色,带或不带黑色中心,有些菌株可呈现大的带光泽的黑色中心,或呈现全部黑色的菌落;有些菌株为黄色菌落,带或不带黑色中心。
沙门菌在XLD上大致可分为四种形态:①菌落呈无色或红色,中心带黑色或全黑;②菌落呈无色或红色,不带黑色中心;③黄色菌落,带黑色中心;④黄色菌落,不带黑色中心。
形态①:菌落呈无色或红色,中心带黑色或全黑。
![]() |
![]() |
|
XLD-鼠伤寒沙门氏ATCC14028 |
XLD-肠炎沙门氏菌CMCC50760 |
多数沙门氏菌可产硫化氢,不分解乳糖和蔗糖,在XLD平板上菌落呈现无色或红色,有黑色中心(如图鼠伤寒沙门氏菌)。部分沙门氏菌可分解XLD培养基中的少量木糖产酸,赖氨酸脱羧反应迟缓,培养早期可观察到菌落周围略微偏黄(如图肠炎沙门氏菌),培养后期分解赖氨酸产碱可使菌落周围变回红色。一些产硫化氢的其他菌属可在此培养基上生长,菌落有黑色中心,为常见干扰菌。
形态②:菌落呈无色或红色,不带黑色中心。
XLD-甲型副伤寒沙门菌CMCC50093
少数沙门氏菌不产硫化氢,不发酵乳糖,在XLD平板上36℃培养18-24h后菌落呈无色或红色,无黑色中心。志贺氏菌属与不产硫化氢、乳糖阴性的沙门氏菌类似,在XLD平板上也呈现为无色或红色,无黑色中心的菌落。XLD平板也用于志贺氏菌的选择性分离培养,不产硫化氢的沙门菌与志贺氏菌形态非常相似,互为干扰菌。假单胞菌属、产碱杆菌属等在XLD上也为无色或淡红色透明菌落,一般通过三糖铁试验可以排除。
形态③:黄色菌落,有黑色中心;:黄色菌落,无黑色中心。
![]() |
![]() |
|
XLD-奇异变形杆菌CMCC49005 |
XLD-大肠埃希氏菌ATCC25922 |
细菌分解培养基中的乳糖或蔗糖产大量酸,菌落显黄色。沙门氏菌中,只有部分亚利桑那沙门氏菌可直接分解乳糖产酸。一些细菌可产硫化氢,在菌落中心呈现黑色。但若细菌产酸过多,有时会阻止硫化氢与铁盐反应,因此一些产硫化氢的细菌在XLD上部分菌落无黑色中心,需要通过三糖铁琼脂进行判断。
部分可直接发酵乳糖的亚利桑那沙门氏菌在XLD平板上菌落呈黄色,有或无黑色中心(乳糖迟缓发酵型的亚利桑那沙门氏菌菌落依然显无色或红色,有黑色中心)。大肠菌群、普通变形杆菌等发酵乳糖或蔗糖的细菌在XLD平板上菌落也呈黄色,有或无黑色中心,为常见干扰菌。
在XLD平板上进行可疑菌落选取时,优先级顺序为:有黑色中心的红色或无色菌落>无黑色中心的红色或无色透明菌落>有黑色中心的黄色菌落>无黑色中心的黄色菌落。详情参考XLD培养基试验原理及现象。
(3)HE琼脂
HE琼脂与XLD琼脂的配方和原理相似,试验现象也与XLD基本一致,因此在实际检样时,HE与XLD选一种即可。
![]() |
|
|
![]() |
|
HE-鼠伤寒沙门氏菌ATCC14028 |
|
|
HE-甲型副伤寒沙门菌CMCC50093 |
|
|
|
|
|
![]() |
|
|
![]() |
|
HE-奇异变形杆菌CMCC49005 |
|
|
HE-福氏志贺氏菌ATCC12022 |
|
|
|
|
|
![]() |
|
|
![]() |
|
HE-普通变形杆菌ATCC13315 |
|
|
HE-大肠埃希氏菌ATCC25922 |
典型沙门氏菌在HE平板上呈无色或蓝绿色透明菌落,有黑色中心;不产硫化氢的沙门氏菌在HE平板上呈无色或蓝绿色透明菌落,无黑色中心;少数可发酵乳糖的亚利桑那沙门氏菌在HE平板上显橙黄色菌落,有或无黑色中心。
在HE平板上挑取可疑菌落优先顺序为:无色或淡绿色透明,黑色中心菌落>无色或淡绿色透明菌落>黄色带黑色中心菌落。
详情参考HE琼脂原理及现象。
(4)沙门菌显色培养基
HE、XLD等传统培养基主要是依照沙门氏菌的生化反应来进行筛选,部分沙门菌落特征不典型及受多种肠道菌干扰,检出率较低,易出现漏检。沙门菌显色培养基原理与传统培养基不同,采用的是酶-底物法进行筛选,特异性高,适用范围广,抗干扰强。特别是检验中遇到不产硫化氢等非典型的沙门氏菌时,显色培养基比传统培养基检出率高很多。
有关沙门氏菌详情参考沙门氏菌显色培养基介绍。
在沙门菌显色培养基上,沙门氏菌菌落显紫色或紫红色。

鼠伤寒沙门氏菌ATCC14028
甲型副伤寒沙门菌CMCC50093
变形杆菌属、志贺氏菌属等不发酵乳糖的细菌菌落呈无色、白色或灰色。

奇异变形杆菌CMCC49005
福氏志贺氏菌ATCC12022
能发酵乳糖的大肠菌群菌落呈蓝色或蓝绿色。
大肠埃希氏菌ATCC25922
四、总结
1、样品处理、增菌、分离培养时,需严格进行无菌操作,防止外来污染;
2、培养基的培养温度、时间需严格按照标准规定执行;
3、进行可疑菌落挑选时,优先选取典型菌落,其次再选择非典型菌落,多种培养基结合使用,可提高检出率。
注:本文属海博生物原创,未经允许不得转载。
